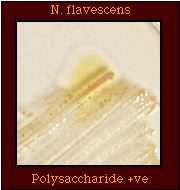
Polysaccharide

Neisseria flavescens
Introduction
N. flavescens was isolated during an outbreak of epidemic meningitis in Chicago and may not have been isolated since. Although reports of the isolation of N. flavescens have been published subsequently, insufficient differential tests were performed to identify the isolates conclusively. These latter isolates may have been N. cinerea.
It is also possible that N. flavescens was a hybrid organism which has characteristics of both the pathogenic and the commensal species. Similar to the saccharolytic species, N. flavescens strains are pigmented, susceptible to colistin, and produce polysaccharide from sucrose but, based on DNA-DNA hybridization studies, N. flavescens is related to the pathogenic Neisseria species.
Images of colony morphology and results of biochemical tests have been included to aid the audience in recognizing and differentiating among Neisseria and related species.
Table 1. Characteristics of N. flavescens
| Characteristic | Illustration |
|---|---|
| Gram stain Cell Morphology | Gram-negative diplococcus |
| Colony Morphology |  |
| Pigmentation |  |
| Oxidase Test |  |
| Acid Production |  No detectable acid from carbohydrates |
| Enzyme Substrate Test | Prolyl aminopeptidase +ve |
| Nitrate Reduction Test | Nitrate -ve |
| Polysaccharide from Sucrose | |
| Production of Deoxyribonuclease (DNase) |  |
| Superoxol Test Reaction with 30% hydrogen peroxide |  Weak positive (2+) reaction |
| Catalase Test Reaction with 3% hydrogen peroxide |  |
| Colistin Resistance |  Colistin-susceptible |
Species which may be misidentified as N. flavescens in acid detection tests
Table 2. Supplemental tests which permit differentiation among gram-negative diplococci that produce no detectable acid from carbohydrates.
| Species that produce no detectable acid | Gram Stain | Enzyme Substrate | DNase | Superoxol | Polysaccharide from sucrose | Nitrate reduction | Colistin susceptibility |
|---|---|---|---|---|---|---|---|
N. flavescens | GND | PAP +ve | - | Weak (2+) reaction | + | - | S |
N. cinerea | GND | PAP +ve | - | Weak (2+) reaction | - | - | (R) |
| (Glucose-negative N. gonorrhoeae) | GND | PAP +ve | - | Strong (4+) reaction | - | - | R |
M. catarrhalis | GND | No reaction | + | Variable strain-dependent (1+ to 4+) reaction | - | + | (R) |
N. elongata | GNR | PAP +ve | - | - | - | - | S |
Abbreviations: GND, gram negative diplococci; GNR, gram negative rods; PAP, prolyl aminopeptidase; +, most strains positive; -, most strains negative; R, strains grow well on selective medium for N. gonorrhoeae and/or show no inhibition around a colistin disk (10 micrograms); (R), most strains susceptible, some strains known to be resistant; S, all strains believed to be susceptible, no strains known to be resistant.
*The reactions shown for the DNase test correspond to the reactions which would be obtained in a lipase test, e.g., tributyrin hydrolysis.
Although enzyme substrate tests are intended to be used only for the identification of Neisseria spp. isolated on selective media for N. gonorrhoeae, these tests do provide additional information that may aid in accurately identifying an isolate. However, N. flavescens produces prolyl aminopeptidase in enzyme substrate test and may be misidentified as N. gonorrhoeae if additional tests are not performed.
Table 3. Supplemental tests which permit differentiation among Neisseria and related species that produce prolyl aminopeptidase in enzyme substrate tests.
| Species that Produce PAP | Cellular Elongation* | Acid from | Nitrate Reduction | Polysaccharide from Sucrose | Superoxol | Colistin Resistance | ||||
|---|---|---|---|---|---|---|---|---|---|---|
| G | M | S | F | L | ||||||
| N. flavescens | Diplococci | - | - | - | - | - | - | + | Weak (2+) positive | S |
| N. cinerea | Diplococci | (-) | - | - | - | - | - | - | Weak (2+) positive | (R) |
| N. gonorrhoeae | Diplococci | + | - | - | - | - | - | - | Strong (4+) positive | R |
| N. gonorrhoeae subspecies kochii | Diplococci | (-) | - | - | - | - | - | - | Strong (4+) positive | R |
| K. denitrificans | Rod filaments | + | - | - | - | - | + | - | - | R |
| N. subflava biovar subflava | Diplococci | + | + | - | - | - | - | - | Weak (2+) positive | S |
| N. subflava biovar flava | Diplococci | + | + | - | + | - | - | - | Weak (2+) positive | S |
| N. subflava biovar perflava | Diplococci | + | + | + | + | - | - | + | Weak (2+) positive | (R) |
| N. sicca | Diplococci | + | + | + | + | - | - | + | Weak (2+) positive | S |
| N. mucosa | Diplococci | + | + | + | + | - | + | + | Weak (2+) positive | S |
| N. elongata | Rod filaments | - | - | - | - | - | - | - | - | S |
Abbreviations: G, glucose; M, maltose, S, sucrose; F, fructose; L, lactose; +, most strains positive; -, most strains negative; (+), strains may give weak positive reactions; R, strains grow well on selective medium for N. gonorrhoeae and/or show no inhibition around a colistin disk (10 micrograms); (R), most strains susceptible, some strains known to be resistant; S, all strains believed to be susceptible, no strains known to be resistant.
References
Bovre K. Family VIII. Neisseriaceae Prevot, In NR Krieg (ed). Manual of Systematic Bacteriology, vol. 1. The Williams & Wilkins co., Baltimore. 1984. p. 288-309.
Branham SA. A new meningococcus-like organism (Neisseria flavescens n. sp.) from epidemic meningitis. Public Hlth Rep 1930;45:845.
Knapp JS. Historical perspectives and identification of Neisseria and related species. Clin Microbiol Rev. 1988;1:415-431.
Knapp JS, Rice RJ. Neisseria and Branhamella. In. Murray PR, Baron EJ, Pfaller MA, Tenover FC, Yolken RH. (ed). Manual of Clinical Microbiology. 6th ed. American Society for Microbiology, Washington D. C, 1995.
Vedros NA. Genus I. Neisseria Trevisan 1885, 105ALIn NR Krieg (ed). Bergey's Manual of Systematic Bacteriology, vol. 1. The Williams & Wilkins Co., Baltimore. 1984. , p. 290-296.
- Page last reviewed: March 31, 2017
- Page last updated: October 17, 2008
- Content source:


 ShareCompartir
ShareCompartir